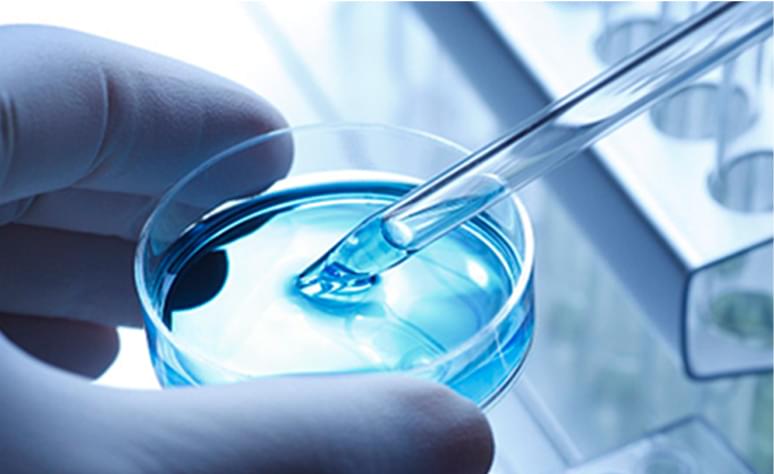

今承达·合同管理
应用场景介绍
销售合同
- 与销售系统和产品主数据、客户主数据打通;
- 报价单直接生成合同,产品主数据生成合同标的信息;
- 领导审批能够了解到客户之前采购的信息,快速决策;
- 销售合同文本可以便捷外发编辑,电子签章;
- 根据销售订单,或到了收付节点,及时通知销售人员发起开票和进行催收;
- 通过资金账户和金额,自动匹配到款与合同,合同数据成为销售业绩的基础。
采购合同
- 与招投标系统和供应商主数据、物料主数据打通;
- 中标结果触发合同起草,采购标的、中标企业信息自动获取,避免信息错误;
- 供应商资信、历史合同履约信息都能够查看到,可以便捷核验供应商身份;
- 根据不同的采购产品的类型,业务审核、财务审核、法务审核、高层审批,实现采购管理制度的落地;
- 采购合同付款可根据采购物料订单情况、收货情况或者合同交期发起付款提醒,告知供应商开票,经办人提交付款申请,合同付款同预算、收货情况等等相关联,防止错付,实现三单匹配;
- 采购合同数据能够与资金相结合,指导资金准备。
人事合同
- 融入人员入职和续签场景,标准化人事合同模板;
- 到时自动提醒人事发起合同签署与续签流程,根据约定的岗位、薪资信息,自动生成合同文本;
- 通过移动端或者短信、邮件发送给相关人员;
- 通过身份认证核验和电子签,可以快速完成人事合同的签署,无需线下打印、快递、人工追踪,异地人事合同签署变得容易;
- 帮助人事部门减少重复工作,不断提高工作效率,将精力放到为企业更好的获取和培养人才上。
投资合同
- 与项目池、资金池以及投委会流程打通;
- 按照投委上会项目信息编制投资合同,确认投资标的与质押信息,明确放款的进度与项目的进度要求;
- 合同审批、签署时,充分展现项目背景信息、历史投资案例信息、明确风险;
- 与项目相结合,按照项目进度,依据合同要求进行放款审核和执行;
- 随时监控项目风险、行业风险以及投资标的风险,一旦出现问题,及时预警,并冻结放款执行;
- 能够按照投资项目,构建投资合同执行情况明细报表;
- 投后对于合同后评估,相关风险写入项目风险库中。
租赁合同
- 租赁合同包括房屋租赁、商铺租赁、土地租赁、厂房租赁、设备融资租赁等;
- 明确租赁物品、租赁期限、租赁用途、租金支付方式、租赁物的维修等等,通过标准范本套用生成合同文本;
- 能够按照合同租赁规则,自动计算固定租金、营业提成、物业费用以及其他费用,能够明确记录代付代缴,按照年、季、月等周期明确资金准备;
- 租赁合同一般涉及时间周期较长,需要明确合同执行期间违约处置情况,时刻跟踪相对方的资信、投资结构等的变动;
- 租赁合同到期或自然年能够自动提前提醒,是否续签续缴;
- 合同终止的时候,能够展现租赁物原拆原还要求。
工程合同
- 提供工程合同场景中从EPC/PC合同到专业分包、劳务分包、物料分包合同等完整合同业务场景的支撑。
- EPC合同前端营销系统对接,实现合同清单、价格等数据的获取,再通过合同谈判策略、谈判磋商,确认工程关键信息。
- 工程清单、进度、概算等关键信息融入合同文本中,实现合同业务评审、财务法务审核 、高层审批,最终用印。
- 签署完成的合同转化为合同台账,后续合同履约、相关分包合同、经济签证、收付信息等都能够记录到工程合同卡片中。
- 项目进度工程量结算与合同相关联,实现按照工程产值进行工程结算与收付款。
- 同时,无论是EPC合同还是分包合同,都时刻关注合同的工程进度、成本、质量风险。
今承达·合同管理
行业方案介绍